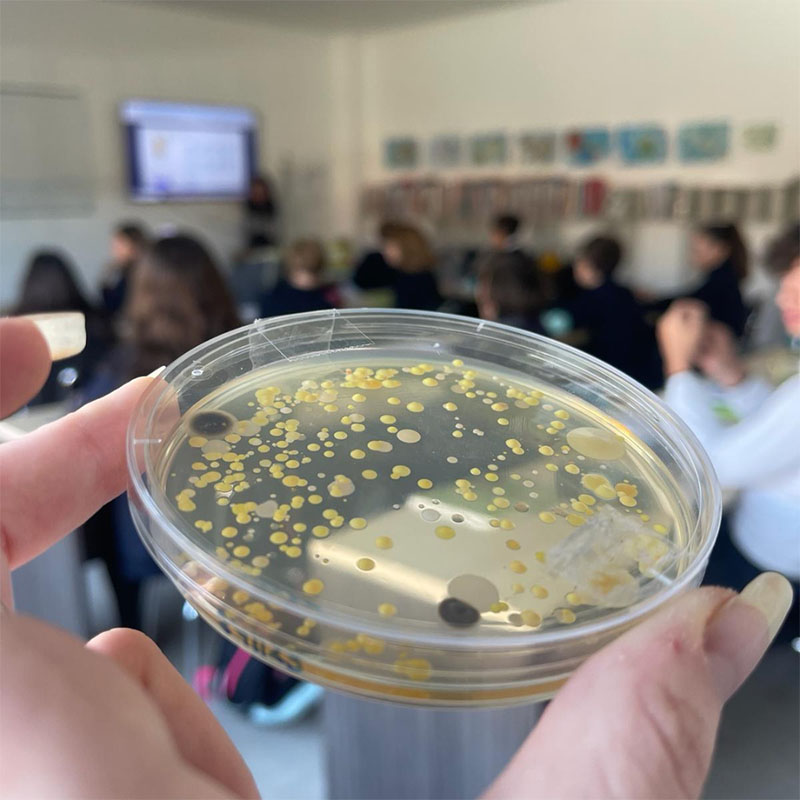
moleculas summer camp

Summer Urban Camp
6 semanas, 6 aventuras. Todo en inglés. Diversión asegurada.


Junio y Julio
¿Buscas un campamento de verano donde tu hijo aprenda, se divierta y haga amigos?
En nuestro Summer Urban Camp bilingüe, cada semana es diferente. Está pensada para que los niños aprendan en inglés mientras juegan, crean y experimentan junto a su grupo. Con actividades adaptadas a su edad y excursiones, descubren el mundo, hacen amigos y se lo pasan en grande. Cada semana está tematizada y enfocada a potenciar diferentes habilidades. Todo en un entorno seguro y lúdico. ¡Te esperamos!
📅 Del 24 de junio al 31 de julio.
🕘 Horario de 9:00 a 14:00 h.
🎯 Inscripción por semanas: ¡elige una, dos o las seis! Hasta el 15 de junio.
🧒 Para niños y niñas de 4 a 11 años.


Around the World Adventure
A través de juegos, arte, música y actividades en inglés, los niños exploran diferentes culturas, desarrollan su creatividad, mejoran la comunicación y aprenden a trabajar en equipo. Todo en un ambiente divertido, respetando el ritmo y el talento de cada uno.
Esta semana está diseñada para estimular las inteligencias interpersonal, lingüística, musical, naturalista y visual-espacial.
Mapamundi interactivoy banderas del mundo
Crea tu instrumento y karaoke cultural
Juegos tradicionales del mundo (rayuela, tag, kabaddi)
Time Travelers
A través del juego, el arte y la ciencia, los niños descubrirán inventos, explorarán momentos clave de la historia y desarrollarán creatividad, pensamiento crítico y emoción por aprender. Todo en un entorno divertido donde se fomenta la imaginación, la expresión y el trabajo en equipo.
Pinturas rupestres y escudos medievales
Inventos de la historia y evolución tecnológica
Simula tu viaje con realidad aumentada
Música de las cavernas vs música futurista


Super Science Lab
Donde la ciencia se mezcla con la diversión
En nuestro campamento, se va a manchar las manos, va a experimentar, mezclar, probar, observar… ¡y alucinar!
Jugando y descubriendo, aprenderá sobre ciencia sin darse cuenta, rodeado de amigos y con muchas ganas de pasarlo bien.
Esta semana está diseñada para potenciar principalmente las inteligencias lógico-matemática, naturalista, visual-espacial y corporal-cinestésica.
Música molecular
Clasificación de materiales
Exploración con microscopio

Reserva antes del 15 de junio
Green Planet
Vamos a crear un huerto urbano, cuidar plantas, reciclar, experimentar con la naturaleza y aprender a través del juego. Todo en inglés, con un enfoque práctico, artístico y científico. Esta semana refuerza las inteligencias naturalista, corporal-cinestésica, intrapersonal y visual-espacial.
Además de pasarlo genial, desarrollarán valores como la paciencia, el cuidado, la responsabilidad y el respeto por el entorno.
Huerto urbano diario: siembra, riego, registro
Macetas decoradas con material reciclado
Video- campaña ambiental y juegos sobre sostenibilidad
Percusión reciclada y música natural





Little Chefs, Big Ideas!
Esta semana en el campamento se mete en la cocina… ¡sin fuego y con mucha creatividad!
A través del juego sensorial, la manipulación de ingredientes y actividades por estaciones, los niños descubrirán cómo cuidar su cuerpo desde lo que comen. Aprenderán a preparar snacks saludables, a explorar sabores y texturas, y a pensar por sí mismos sobre lo que ponen en su plato.
Todo en un entorno divertido, seguro y en inglés, donde también desarrollan autonomía, responsabilidad y conciencia corporal.
Clasificación de alimentos y experimentos con texturas
Diseño de platos y menú saludable
Creación de ritmos con utensilios de cocina
Showtime!
Cámara, emoción... ¡y acción!
Si a tu hijo le encanta cantar, moverse, inventar personajes o simplemente expresarse, esta es su oportunidad de formar parte de algo único.
Durante cinco días vivirán el proceso de crear una obra en grupo: música, teatro, baile, artes visuales y mucha emoción. Cada uno aporta su talento, gana confianza y aprende el valor de trabajar en equipo, siempre en un entorno seguro, creativo y en inglés.
El escenario se convierte en su aula. ¿Te imaginas su cara cuando se vea en escena? ¡Luces, cámara y a escena!
Decorado, escenografía, maquillaje, entradas
Grabación de voces y efectos visuales
Coreografía y expresión corporal


Un verano, sin sorpresas
1 Semana (9:00–14:00): 130 €
2 Semanas (9:00–14:00): 250 €
3 Semanas (9:00–14:00): 325 €
4 Semanas (9:00–14:00): 330 €
5 Semanas (9:00–14:00): 345 €
6 Semanas (9:00–14:00): 350 €
Los precios indicados son por niño/a.
En todas las semanas, las excursiones están excluidas del precio.
La reserva de la plaza supone 10€ que se descontarán del precio total. Si traes a tu amigo (externo) y se matricula, te llevas 10€ de descuento.

¿Tienes dudas? Te las resolvemos
¿Cuántas semanas puedo incribirse?
Puedes elegir las semanas que mejor se adapten a tu verano, desde 1 semana hasta las 6 semanas.
¿Todo es en inglés?
Sí, pero adaptado a su edad y nivel. Lo viven de forma natural y divertida.
¿Los niños se agrupan por edad?
Sí, por franjas, para que estén cómodos, se diviertan y aprendan a su ritmo.
¿Qué tiene que llevar cada día?
Solo ropa cómoda, una gorra, botella de agua y un snack saludable para el almuerzo.
Si no soy alumno/a del colegio, ¿puedo inscribirme?
Por supuesto que sí. Además, si eres alumno/a y traes a un amigo/a al campamento, te llevas 10€ de descuento.

Un verano lleno de aprendizaje y diversión... sin que tengas que planearlo tú
Responsable de tus datos: María Nebrera Ruiz S.A. Finalidad: Respuestas y correos electrónicos comerciales. Legitimación; es gracias a tu consentimiento. Destinatarios: tus datos se encuentran alojados en Arsys Internet S.L.U. Tus Derechos: Acceso, Rectificación, Limitación o Suprimir tus datos en administracion@colegiomarianebrera.es *










